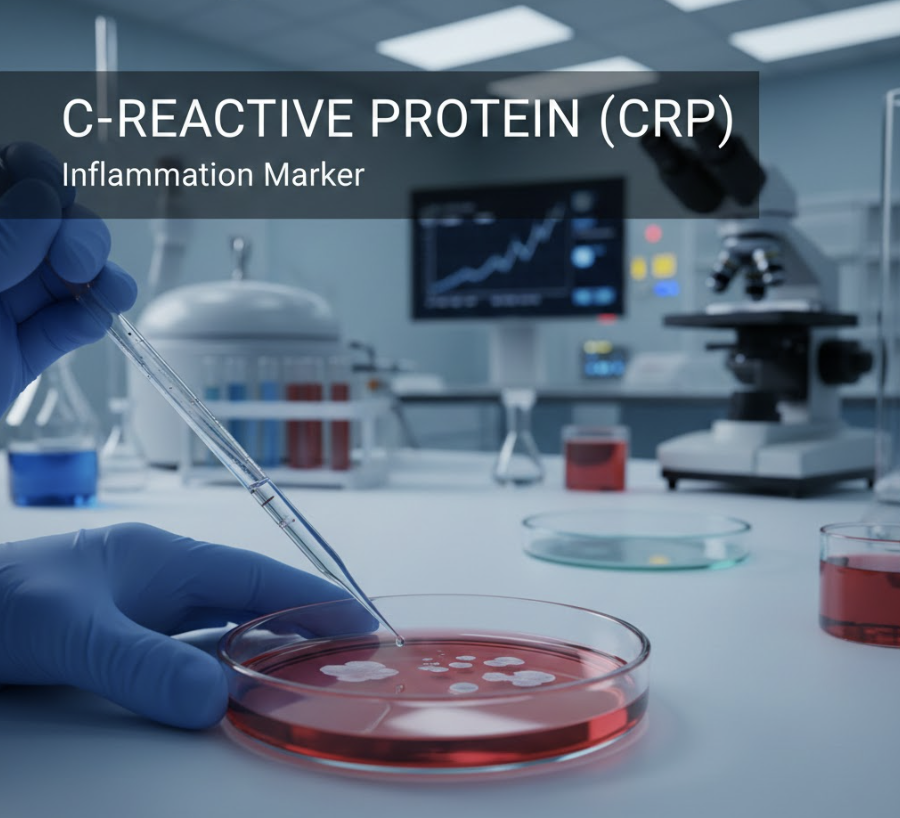

Twój koszyk jest obecnie pusty!
Odczyn Biernackiego
OB – dwie litery, które mogą uratować Twoje zdrowie!
Czym jest Odczyn Biernackiego, w skrócie OB, to badanie laboratoryjne oceniające szybkość opadania czerwonych krwinek, czyli erytrocytów, w specjalnie przygotowanej probówce w określonym czasie. Jego nazwa pochodzi od nazwiska polskiego lekarza, Edmunda Biernackiego, który jako pierwszy odkrył zależność między tempem opadania erytrocytów a stanem zapalnym w organizmie.
OB jest badaniem prostym, tanim i szeroko dostępnym, co czyni go powszechnie stosowanym narzędziem diagnostycznym. Mimo że nie wskazuje ono na konkretną chorobę, podwyższona wartość OB może sugerować obecność stanu zapalnego, infekcji, choroby autoimmunologicznej, a nawet nowotworu.
Wartość diagnostyczna OB wynika z faktu, że w przebiegu wielu chorób dochodzi do zmian w składzie białek osocza krwi. Wzrost stężenia tzw. białek ostrej fazy, które pojawiają się we krwi w odpowiedzi na stan zapalny, wpływa na zwiększenie szybkości opadania erytrocytów.
Interpretacja wyników OB zawsze powinna odbywać się w kontekście objawów klinicznych pacjenta, historii choroby oraz wyników innych badań diagnostycznych.
Co to jest badanie OB?
Badanie OB, czyli odczyn Biernackiego, to badanie laboratoryjne, które mierzy, jak szybko czerwone krwinki (erytrocyty) opadają na dno probówki w ciągu jednej godziny. Im szybciej krwinki opadają, tym wyższa jest wartość OB, co może wskazywać na stan zapalny w organizmie.
Wzrost OB wynika ze zmian w składzie białek krwi, do których dochodzi w przebiegu procesów zapalnych. Białka te powodują „sklejanie się” erytrocytów i tworzenie tzw. agregatów, które opadają szybciej niż pojedyncze komórki.
Należy podkreślić, że badanie OB ma charakter niespecyficzny. Oznacza to, że nie wskazuje ono na konkretną chorobę, a jedynie sugeruje istnienie stanu zapalnego, który może być spowodowany przez wiele czynników, takich jak infekcje, choroby autoimmunologiczne, a nawet nowotwory. Dlatego też interpretacja wyniku OB zawsze wymaga uwzględnienia objawów klinicznych pacjenta, jego historii choroby oraz wyników innych badań diagnostycznych.
Jakie są normy badania OB?
Norma badania OB, czyli zakres wartości uznawanych za prawidłowe, może się różnić w zależności od laboratorium wykonującego badanie, a także stosowanej metodyki. Zazwyczaj jednak przyjmuje się następujące wartości referencyjne:
- Mężczyźni: do 10 mm/h
- Kobiety: do 15 mm/h
- Noworodki: do 2 mm/h
- Dzieci do 10 roku życia: 3-10 mm/h
Wartości powyżej tych norm są uważane za podwyższone i mogą wskazywać na obecność stanu zapalnego w organizmie.
Należy jednak pamiętać, że OB jest badaniem niespecyficznym, co oznacza, że podwyższony wynik nie zawsze musi świadczyć o chorobie. Istnieje wiele czynników, które mogą wpływać na przyspieszenie opadania erytrocytów, takich jak:


- Fizjologiczne: ciąża, menstruacja, wiek (u osób starszych OB może być fizjologicznie podwyższone)
- Czynniki zewnętrzne: stres, intensywny wysiłek fizyczny, niektóre leki
- Czynniki indywidualne: otyłość, niedokrwistość, zaburzenia lipidowe
Dlatego też interpretacja wyników OB zawsze powinna odbywać się w oparciu o całokształt obrazu klinicznego pacjenta, uwzględniając jego objawy, historię choroby oraz wyniki innych badań. Samodzielna interpretacja wyników OB może być błędna i prowadzić do niepotrzebnego niepokoju lub opóźnienia w rozpoznaniu innych schorzeń.
Przyczyny nieprawidłowych wyników
Odczyn Biernackiego (OB), choć nie jest badaniem specyficznym, może dostarczyć cennych informacji na temat stanu zdrowia pacjenta. Zarówno wartości OB przekraczające przyjęte normy, jak i te niższe od nich, mogą wskazywać na różne problemy zdrowotne.
Do najczęstszych przyczyn podwyższonego OB należą stany zapalne o różnej etiologii. W przebiegu infekcji bakteryjnych, wirusowych czy grzybiczych dochodzi do aktywacji układu odpornościowego i produkcji białek zapalnych. To bezpośrednio wpływa na zwiększenie szybkości opadania erytrocytów. Podobny mechanizm obserwuje się w chorobach autoimmunologicznych, takich jak reumatoidalne zapalenie stawów czy toczeń. Tam dochodzi do nieprawidłowej odpowiedzi immunologicznej skierowanej przeciwko własnym tkankom.
Należy również pamiętać, że nowotwory, szczególnie te o charakterze złośliwym, również mogą powodować wzrost OB. Wzrost ten wynika z produkcji mediatorów zapalnych przez komórki nowotworowe lub w reakcji na ich obecność.
Oprócz powyższych, istnieje szereg innych czynników, które mogą wpływać na wynik OB. Do najważniejszych należą:
- Czynniki fizjologiczne: wiek (u osób starszych OB może być fizjologicznie podwyższone), ciąża, menstruacja.
- Czynniki zewnętrzne: stres, palenie tytoniu, intensywny wysiłek fizyczny, przyjmowanie niektórych leków (np. antykoncepcji hormonalnej).
- Czynniki indywidualne: otyłość, niedokrwistość, zaburzenia gospodarki lipidowej.
Z kolei obniżone OB, choć rzadsze, również może wskazywać na pewne nieprawidłowości. Do przyczyn niskiego OB zalicza się m.in. :
- Zaburzenia krzepnięcia krwi: np. hemofilia, choroba von Willebranda.
- Nieprawidłowa morfologia erytrocytów: np. sferocytoza, talasemia.
- Choroby zmniejszające stężenie białek w osoczu: np. nadczynność tarczycy, zespół nerczycowy.
W każdym przypadku nieprawidłowego wyniku OB konieczna jest konsultacja lekarska w celu ustalenia przyczyny i wdrożenia odpowiedniego postępowania.
Objawy związane z nieprawidłowym OB:
Należy pamiętać, że sam OB nie wywołuje objawów. Podwyższony OB jest jedynie wskaźnikiem, który może sugerować obecność stanu zapalnego w organizmie. Objawy, które możemy obserwować, są spowodowane przez samą chorobę lub stan, który wywołuje wzrost OB, a nie przez podwyższone OB samo w sobie.
Do najczęstszych objawów, którym może towarzyszyć podwyższone OB, zaliczamy:
- Gorączka: Jest to jeden z najczęstszych objawów stanu zapalnego i może towarzyszyć szerokiemu spektrum chorób infekcyjnych i nieinfekcyjnych.
- Ból: Lokalizacja i nasilenie bólu zależą od przyczyny stanu zapalnego. Może to być ból ostry lub przewlekły, np. ból stawów, mięśni, głowy, brzucha.
- Zmęczenie i osłabienie: To niespecyficzne objawy, które mogą występować w przebiegu wielu chorób, w tym tych przebiegających ze stanem zapalnym.
- Utrata apetytu i spadek masy ciała: Mogą świadczyć o rozległym procesie chorobowym i wymagają szczegółowej diagnostyki.
- Obrzęk i zaczerwienienie: Typowe objawy miejscowego stanu zapalnego, np. w miejscu infekcji skóry.
- Powiększenie węzłów chłonnych: Węzły chłonne są częścią układu odpornościowego i powiększają się w odpowiedzi na infekcje lub inne procesy chorobowe.
Niskie OB samo w sobie zazwyczaj nie wywołuje żadnych objawów i nie jest wskazówką do specjalnego postępowania.


W przypadku wystąpienia któregokolwiek z powyższych objawów należy skonsultować się z lekarzem. Pamiętajmy, że są to tylko przykłady, a pełna lista objawów zależy od konkretnej choroby lub stanu chorobowego.
Jak się przygotować do badania OB?
Przygotowanie do badania OB jest minimalne i zazwyczaj nie wymaga specjalnych procedur. Istnieje jednak kilka czynników, które mogą wpłynąć na wynik OB, dlatego warto je wziąć pod uwagę przed badaniem.
Po pierwsze, warto poinformować lekarza o wszystkich przyjmowanych lekach, suplementach diety i ziołach. Niektóre z nich mogą wpływać na wynik OB, zarówno go podwyższając, jak i obniżając.
W przeciwieństwie do niektórych innych badań krwi, nie ma potrzeby bycia na czczo przed badaniem OB. Można spożywać posiłki i napoje według swojego zwyczaju.
Mimo, że nie ma naukowych dowodów na wpływ stresu na wynik OB, w trosce o komfort psychiczny pacjenta, zaleca się unikanie stresujących sytuacji przed badaniem.
W przypadku wątpliwości, zawsze warto skonsultować się z lekarzem lub personelem laboratorium w celu uzyskania szczegółowych informacji dotyczących przygotowania do badania OB.
Jak przebiega badanie OB?
Badanie OB jest stosunkowo prostą procedurą, która zazwyczaj nie zajmuje dużo czasu. Polega na pobraniu próbki krwi żylnej, zazwyczaj z żyły w zgięciu łokciowym.
Pobrana krew odstawiana jest na okres jednej godziny w czasie której erytrocyty, czyli czerwone krwinki, pod wpływem siły grawitacji zaczynają powoli opadać na dno probówki, tworząc widoczną granicę między osoczem a opadającymi krwinkami. Po upływie godziny technik laboratoryjny odczytuje z podziałki na probówce odległość (wyrażoną w milimetrach), jaką pokonały erytrocyty.
Wynik badania OB wyraża się w milimetrach na godzinę (mm/h) i odzwierciedla szybkość opadania erytrocytów. Im wyższa wartość OB, tym szybciej krwinki opadają na dno probówki, co może wskazywać na obecność stanu zapalnego w organizmie. Należy jednak pamiętać, że badanie OB ma charakter niespecyficzny i podwyższony wynik nie zawsze musi oznaczać chorobę.
Nieprawidłowe wyniki OB – jak interpretować?
Odczyn Biernackiego (OB) to niespecyficzny marker stanu zapalnego, co oznacza, że jego podwyższona wartość nie wskazuje na konkretną chorobę, ale sugeruje, że w organizmie toczy się proces zapalny. Podobnie jak w przypadku podwyższonego OB, wynik niższy od normy nie jest rozstrzygający i wymaga uwzględnienia szerszego kontekstu klinicznego.


Interpretacja nieprawidłowych wyników OB zawsze powinna odbywać się w oparciu o całokształt obrazu klinicznego pacjenta. Do najważniejszych elementów, które lekarz bierze pod uwagę podczas analizy wyników, należą:
- Objawy kliniczne: Rodzaj, nasilenie i czas trwania objawów dostarczają ważnych wskazówek co do potencjalnej przyczyny nieprawidłowego OB.
- Historia choroby: Przewlekłe choroby, niedawno przebyte infekcje lub zabiegi chirurgiczne mogą mieć wpływ na wynik OB.
- Leki: Niektóre leki, takie jak antykoncepcja hormonalna czy glikokortykosteroidy, mogą wpływać na OB.
- Wyniki innych badań: Morfologia krwi, CRP, badania obrazowe lub inne testy laboratoryjne pomagają w zróżnicowaniu przyczyn nieprawidłowego OB.
W przypadku wątpliwości co do interpretacji wyników OB konieczna jest konsultacja z lekarzem. Samodzielna interpretacja wyników może być błędna i prowadzić do nieuzasadnionego niepokoju lub opóźnienia we wdrożeniu odpowiedniego leczenia.
Leczenie i zapobieganie problemom z nadmiernym bądź zbyt niskim OB
W kontekście odczynu Biernackiego (OB) należy pamiętać, że nie jest to samodzielna jednostka chorobowa, lecz niespecyficzny marker stanu zapalnego. Oznacza to, że nieprawidłowe wartości OB – zarówno zbyt wysokie, jak i zbyt niskie – same w sobie nie są leczone. Kluczowe jest zdiagnozowanie i leczenie przyczyny, która leży u podstaw zaburzeń.
W przypadku podwyższonego OB terapia będzie uzależniona od etiologii stanu zapalnego. Może ona obejmować:
- Leczenie przyczynowe: W przypadku infekcji bakteryjnych stosowana jest antybiotykoterapia. W infekcjach wirusowych – leki przeciwwirusowe, a w chorobach autoimmunologicznych – leki immunosupresyjne lub terapia biologiczna.
- Leczenie objawowe: W celu złagodzenia objawów stanu zapalnego, takich jak ból czy gorączka, stosuje się leki przeciwbólowe i przeciwgorączkowe, np. niesteroidowe leki przeciwzapalne (NLPZ).
Natomiast obniżone OB samo w sobie zazwyczaj nie jest wskazaniem do leczenia. Chyba że towarzyszą mu inne nieprawidłowości w badaniach laboratoryjnych lub objawy kliniczne.
Profilaktyka zaburzeń OB opiera się na prowadzeniu zdrowego stylu życia, co przekłada się na wzmocnienie odporności i zmniejszenie ryzyka rozwoju chorób przewlekłych. Do najważniejszych elementów zdrowego stylu życia należą:
- Zrównoważona dieta: Bogata w warzywa, owoce, produkty pełnoziarniste, zdrowe tłuszcze i białko, a uboga w produkty przetworzone, cukier i sól.
- Regularna aktywność fizyczna: Co najmniej 30 minut umiarkowanego wysiłku fizycznego przez większość dni w tygodniu.
- Utrzymywanie prawidłowej masy ciała: Ograniczenie ryzyka rozwoju otyłości, cukrzycy typu 2 i innych chorób metabolicznych.
- Unikanie używek: Palenia tytoniu i nadmiernego spożycia alkoholu.
- Regularne badania kontrolne: Pozwalają na wczesne wykrycie i leczenie chorób, zanim dojdzie do rozwoju powikłań.
Pamiętajmy, że OB to tylko jeden z elementów układanki diagnostycznej. Jego interpretacja powinna odbywać się w kontekście całokształtu obrazu klinicznego pacjenta, z uwzględnieniem objawów, historii choroby oraz wyników innych badań.
Suplementacja a odczyn Biernackiego
Należy wyraźnie zaznaczyć, że nie istnieją żadne suplementy diety przeznaczone stricte do modyfikowania odczynu Biernackiego (OB). OB jest jedynie wskaźnikiem, który odzwierciedla zachodzące w organizmie procesy, a nie stanem samym w sobie. Zamiast skupiania się na bezpośrednim wpływie suplementów na OB, ważne jest, aby zrozumieć, jak ogólny stan zdrowia i styl życia wpływają na ten wskaźnik.
Mimo że suplementacja nie jest w stanie zastąpić leczenia lub zrekompensować niezdrowego stylu życia, to odpowiednio dobrane preparaty, przyjmowane pod kontrolą lekarza, mogą stanowić cenne wsparcie dla organizmu w przypadku nieprawidłowości OB.
Przykładowo, w stanach zapalnych, które często manifestują się podwyższonym OB, pomocne mogą okazać się suplementy o działaniu przeciwzapalnym, takie jak:


- Kwasy tłuszczowe omega-3: Wykazują korzystny wpływ na układ odpornościowy i pomagają łagodzić stany zapalne.
- Kurkumina: Aktywny składnik kurkumy, znany ze swoich silnych właściwości przeciwzapalnych i antyoksydacyjnych.
- Imbir: Zawiera gingerol, związek o udokumentowanym działaniu przeciwzapalnym i przeciwbólowym.
Natomiast w przypadku obniżonego OB, które może świadczyć o niedoborach pokarmowych, warto rozważyć suplementację:
- Żelazo: Jego niedobór może prowadzić do niedokrwistości, która jest jedną z przyczyn obniżonego OB.
- Witamina B12: Niezbędna do prawidłowej produkcji czerwonych krwinek.
- Kwas foliowy: Wraz z witaminą B12 uczestniczy w procesie krwiotworzenia.
Pamiętajmy, że decyzja o suplementacji powinna być poprzedzona konsultacją z lekarzem, który na podstawie wywiadu, badania fizykalnego i wyników badań laboratoryjnych oceni ewentualne niedobory i zaleci odpowiednie preparaty i ich dawkowanie.
Dieta w przypadku nieprawidłowego OB
W kontekście diety i odczynu Biernackiego (OB) należy pamiętać, że sam OB nie jest bezpośrednio kształtowany przez to, co jemy. Dieta odgrywa jednak kluczową rolę w regulowaniu procesów zapalnych w organizmie, których OB jest wskaźnikiem.
W przypadku podwyższonego OB, które może sugerować obecność stanu zapalnego, zaleca się dietę bogatą w produkty o działaniu przeciwzapalnym. Należą do nich:
- Warzywa i owoce: Dostarczają przeciwutleniaczy, które zwalczają wolne rodniki i chronią komórki przed uszkodzeniami.
- Pełnoziarniste produkty zbożowe: Są źródłem błonnika, który reguluje pracę jelit i wpływa korzystnie na mikrobiotę jelitową, co ma znaczenie dla odporności organizmu.
- Ryby morskie: Bogate w kwasy tłuszczowe omega-3, które wykazują silne działanie przeciwzapalne.
- Oliwa z oliwek, awokado, orzechy: Dostarczają nienasyconych kwasów tłuszczowych, które również działają przeciwzapalnie.
Jednocześnie warto ograniczyć spożycie produktów o potencjale prozapalnym, takich jak:
- Cukier i produkty wysoko przetworzone: Powodują gwałtowne wzrosty poziomu cukru we krwi, co sprzyja stanom zapalnym.
- Tłuszcze nasycone i tłuszcze trans: Występują głównie w produktach odzwierzęcych i wysoko przetworzonej żywności.
- Nadmiar soli: Może nasilać stany zapalne i podnosić ciśnienie krwi.
Natomiast w przypadku obniżonego OB nie ma specjalnych zaleceń żywieniowych. Ważne jest, aby dieta była zrównoważona i dostarczała wszystkich niezbędnych składników odżywczych.
Pamiętajmy, że dieta to tylko jeden z elementów wpływających na stan zapalny w organizmie. W przypadku nieprawidłowych wyników OB zawsze należy skonsultować się z lekarzem w celu ustalenia przyczyny i wdrożenia odpowiedniego leczenia.
Badania powiązane z odczynem Biernackiego (OB)
Odczyn Biernackiego (OB) często stanowi punkt wyjścia do dalszych badań diagnostycznych, zwłaszcza gdy jego wynik odbiega od normy. Ze względu na swój niespecyficzny charakter, OB nie pozwala na postawienie jednoznacznej diagnozy, ale może wskazywać na potrzebę pogłębienia diagnostyki w kierunku konkretnych schorzeń.
Wśród badań, które lekarz może zlecić w następstwie nieprawidłowego wyniku OB, znajdują się:
- Morfologia krwi z rozmazem: To podstawowe badanie krwi dostarcza informacji o liczbie i morfologii różnych typów komórek krwi – erytrocytów, leukocytów i trombocytów. Pozwala to na wykrycie m.in. niedokrwistości, infekcji bakteryjnych i wirusowych, a także niektórych nowotworów krwi.
- CRP (białko C-reaktywne): To badanie, podobnie jak OB, jest markerem stanu zapalnego, ale cechuje się większą czułością i szybkością reakcji. Wzrost CRP następuje zwykle w ciągu kilku godzin od wystąpienia czynnika zapalnego, co czyni go przydatnym narzędziem w monitorowaniu przebiegu choroby i skuteczności leczenia.
- Panel autoimmunologiczny: W przypadku podejrzenia choroby autoimmunologicznej, lekarz może zlecić badania w kierunku przeciwciał charakterystycznych dla danego schorzenia, np. przeciwciał przeciwjądrowych (ANA) w toczniu rumieniowatym układowym lub czynnika reumatoidalnego (RF) w reumatoidalnym zapaleniu stawów.
- Badania obrazowe: W zależności od podejrzewanej przyczyny nieprawidłowego OB, lekarz może zlecić badania obrazowe, takie jak USG, RTG, tomografia komputerowa lub rezonans magnetyczny. Pozwalają one na uwidocznienie zmian w narządach wewnętrznych i tkankach, co ułatwia postawienie diagnozy.
Dobór odpowiednich badań zawsze zależy od indywidualnej sytuacji klinicznej pacjenta, uwzględniając jego objawy, historię choroby oraz wyniki badań fizykalnych. Współpraca z lekarzem jest kluczowa dla prawidłowej interpretacji wyników badań i ustalenia odpowiedniego planu leczenia.


Zależności pomiędzy odczynem Biernackiego a innymi badaniami
Odczyn Biernackiego (OB) jest często analizowany w połączeniu z wynikami innych badań laboratoryjnych, aby uzyskać pełniejszy obraz stanu zdrowia pacjenta. Pozwala to na dokładniejszą diagnozę i zaplanowanie odpowiedniego leczenia.
Jednym z najważniejszych badań, które są często rozpatrywane razem z OB, jest stężenie białka C-reaktywnego (CRP). Podobnie jak OB, CRP jest niespecyficznym markerem stanu zapalnego, ale jego stężenie we krwi rośnie znacznie szybciej w odpowiedzi na stan zapalny niż OB. Porównanie wyników OB i CRP może dostarczyć informacji na temat fazy stanu zapalnego – wysokie CRP przy prawidłowym OB może wskazywać na ostry proces zapalny, natomiast wysokie wartości obu markerów mogą sugerować przewlekły stan zapalny.
Oprócz CRP, istotne jest również rozpatrywanie wyniku OB w kontekście wyników morfologii krwi, zwłaszcza liczby leukocytów (białych krwinek) i erytrocytów (czerwonych krwinek) oraz stężenia hemoglobiny. Podwyższona liczba leukocytów w połączeniu z podwyższonym OB może sugerować infekcje bakteryjną, natomiast podwyższone OB przy jednoczesnej niedokrwistości (niskie stężenie hemoglobiny i erytrocytów) może wskazywać na chorobę przewlekłą lub niedobory żywieniowe.
W niektórych przypadkach, lekarz może również zlecić badania dodatkowe, takie jak:
- Elektroforeza białek: Pozwala na rozdzielenie białek osocza krwi i identyfikację ewentualnych nieprawidłowości w ich proporcjach, co może być pomocne w diagnostyce chorób autoimmunologicznych, nowotworowych lub infekcyjnych.
- Badania w kierunku konkretnych infekcji: W zależności od objawów klinicznych, lekarz może zlecić badania w kierunku infekcji bakteryjnych, wirusowych lub pasożytniczych.
- Badania obrazowe: USG, RTG, tomografia komputerowa lub rezonans magnetyczny mogą być pomocne w wizualizacji narządów wewnętrznych i wykrywaniu ewentualnych zmian patologicznych.
Interpretacja wyniku OB powinna zawsze odbywać się w oparciu o całokształt obrazu klinicznego pacjenta, uwzględniając jego objawy, historię choroby oraz wyniki innych badań laboratoryjnych i obrazowych.
Najczęściej zadawane pytania (FAQ)
Co oznacza skrót „OB” i na czym polega to badanie?
OB to skrót od „Odczyn Biernackiego”. To badanie laboratoryjne, które mierzy, jak szybko czerwone krwinki (erytrocyty) opadają na dno probówki w ciągu jednej godziny. Wzrost szybkości opadania może wskazywać na stan zapalny w organizmie.
Czy podwyższony OB zawsze oznacza poważną chorobę?
Nie, podwyższony OB nie zawsze świadczy o poważnej chorobie. Wiele czynników, takich jak infekcje, stres, a nawet miesiączka, może tymczasowo podwyższyć OB. Ważne jest, aby interpretować wynik OB w kontekście innych objawów i badań.
Jakie są najczęstsze przyczyny podwyższonego OB?


Do najczęstszych przyczyn podwyższonego OB należą infekcje bakteryjne i wirusowe, choroby autoimmunologiczne (np. reumatoidalne zapalenie stawów, toczeń), niektóre nowotwory oraz przewlekłe stany zapalne.
Czy istnieją domowe sposoby na obniżenie OB?
Nie ma domowych sposobów na bezpośrednie obniżenie OB. Kluczowe jest zidentyfikowanie i leczenie przyczyny podwyższonego OB. Zdrowy styl życia, w tym zrównoważona dieta i aktywność fizyczna, mogą wspierać naturalne mechanizmy obronne organizmu.
Czy OB może być za niskie? Co to oznacza?
Tak, choć rzadziej, OB może być również obniżone. Może to być spowodowane zaburzeniami krzepnięcia krwi, nieprawidłową morfologią erytrocytów lub chorobami wpływającymi na stężenie białek w osoczu.
Kiedy należy skonsultować się z lekarzem w przypadku nieprawidłowego wyniku OB?
Zawsze należy skonsultować się z lekarzem w przypadku nieprawidłowego wyniku OB, szczególnie jeśli towarzyszą mu inne niepokojące objawy, takie jak gorączka, ból, zmęczenie lub utrata masy ciała.
Podsumowanie
Odczyn Biernackiego (OB), mimo że jest prostym i tanim badaniem laboratoryjnym, odgrywa istotną rolę w diagnostyce medycznej. Jego głównym zadaniem jest ocena szybkości opadania czerwonych krwinek (erytrocytów) w specjalnej probówce, co pozwala na wykrycie toczącego się w organizmie stanu zapalnego.
Należy jednak podkreślić, że OB jest badaniem niespecyficznym, co oznacza, że podwyższony wynik nie wskazuje na konkretną chorobę, a jedynie sugeruje istnienie stanu zapalnego, którego przyczyny mogą być różne – od banalnych infekcji, po choroby autoimmunologiczne, a nawet nowotwory.
Dlatego też interpretacja wyniku OB zawsze powinna odbywać się w oparciu o całokształt obrazu klinicznego pacjenta, z uwzględnieniem jego objawów, historii choroby, przyjmowanych leków oraz wyników innych badań. W przypadku wątpliwości co do interpretacji wyniku OB, należy zawsze skonsultować się z lekarzem, który zaleci odpowiednie postępowanie diagnostyczne i terapeutyczne.


Uzyskaj dedykowaną interpretację wyników krwi na naszej platformie.
Referencje
Current validity of the erythrocyte sedimentation rate.
The erythrocyte sedimentation rate (ESR) in canine inflammation.
The erythrocyte sedimentation rate: old and new clinical applications.
Erythrocyte Sedimentation Rate: Journey Verifying a New Method for an Imperfect Test.